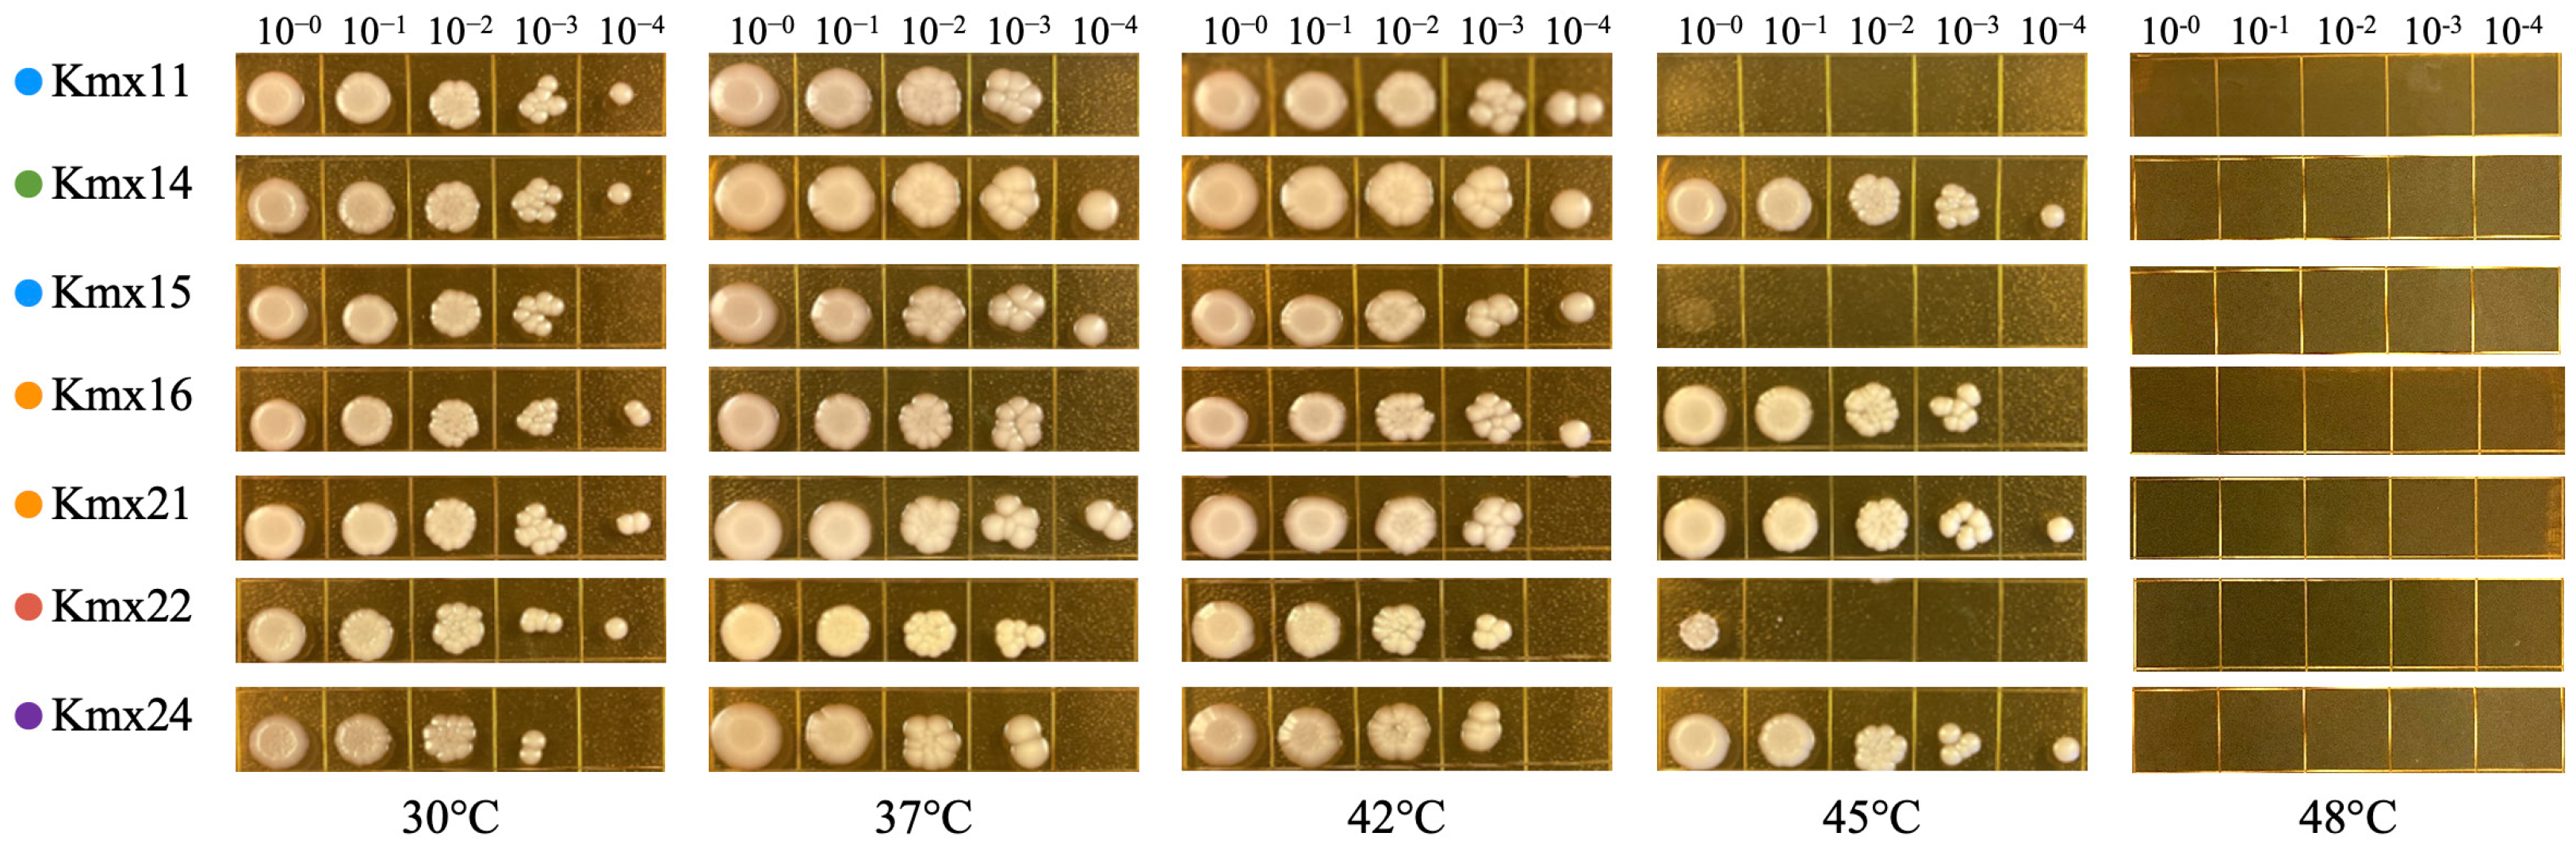
Jof 09 00795 g003

Genotypic and Phenotypic Diversity of Kluyveromyces marxianus Isolates Obtained from the Elaboration Process of Two Traditional Mexican Alcoholic Beverages Derived from Agave: Pulque and Henequen (Agave fourcroydes) Mezcal
Abstract
1. Introduction
2. Materials and Methods
2.1. Yeasts Strains and Growth Conditions
2.2. DNA Extraction, Molecular Identification, and Phylogenetic Analysis
2.3. Microsatellites Analysis
2.4. Morphological and Phenotypical Characterization
2.5. Thermotolerance and Calcofluor White Tolerance Evaluation
2.6. Growth Kinetics at Different Temperatures
2.7. Tolerance to Stress Conditions Relevant for Lignocellulosic Hydrolysates Fermentation
2.8. SSF Tests
2.9. Nucleotide Sequence Accession Numbers
3. Results
3.1. Molecular Identification and Phylogenetic Analysis
3.2. Microsatellites
3.3. Morphology and Carbon Sources Utilization
3.4. Thermotolerance and Growth Profiles at Different Temperatures
3.5. Tolerance to CFW at Different Temperatures
3.6. Tolerance to Stress Conditions Relevant for Bioethanol Production
3.7. SSF of a Corncob Hydrolysate
4. Discussion
5. Conclusions
Supplementary Materials
Author Contributions
Funding
Institutional Review Board Statement
Informed Consent Statement
Data Availability Statement
Acknowledgments
Conflicts of Interest
References
- Fonseca, G.G.; Heinzle, E.; Wittmann, C.; Gombert, A.K. The Yeast Kluyveromyces marxianus and Its Biotechnological Potential. Appl. Microbiol. Biotechnol. 2008, 79, 339–354. [Google Scholar] [CrossRef] [PubMed]
- Lane, M.M.; Morrissey, J.P. Kluyveromyces marxianus: A Yeast Emerging from Its Sister’s Shadow. Fungal Biol. Rev. 2010, 24, 17–26. [Google Scholar] [CrossRef]
- Bilal, M.; Ji, L.; Xu, Y.; Xu, S.; Lin, Y.; Iqbal, H.M.N.; Cheng, H. Bioprospecting Kluyveromyces marxianus as a Robust Host for Industrial Biotechnology. Front. Bioeng. Biotechnol. 2022, 10, 851768. [Google Scholar] [CrossRef]
- Qiu, Y.; Lei, P.; Wang, R.; Sun, L.; Luo, Z.; Li, S.; Xu, H. Kluyveromyces as Promising Yeast Cell Factories for Industrial Bioproduction: From Bio-Functional Design to Applications. Biotechnol. Adv. 2023, 64, 108125. [Google Scholar] [CrossRef] [PubMed]
- Morrissey, J.P.; Etschmann, M.M.W.; Schrader, J.; de Billerbeck, G.M. Cell Factory Applications of the Yeast Kluyveromyces marxianus for the Biotechnological Production of Natural Flavour and Fragrance Molecules. Yeast 2015, 32, 3–16. [Google Scholar] [CrossRef] [PubMed]
- Jach, M.E.; Serefko, A.; Ziaja, M.; Kieliszek, M. Yeast Protein as an Easily Accessible Food Source. Metabolites 2022, 12, 63. [Google Scholar] [CrossRef] [PubMed]
- Nag, D.; Goel, A.; Padwad, Y.; Singh, D. In vitro Characterisation Revealed Himalayan Dairy Kluyveromyces marxianus PCH397 as Potential Probiotic with Therapeutic Properties. Probiotics Antimicrob. Proteins 2022, 15, 761–773. [Google Scholar] [CrossRef]
- Rollero, S.; Zietsman, A.J.J.; Buffetto, F.; Schückel, J.; Ortiz-Julien, A.; Divol, B. Kluyveromyces marxianus Secretes a Pectinase in Shiraz Grape Must That Impacts Technological Properties and Aroma Profile of Wine. J. Agric. Food Chem. 2018, 66, 11739–11747. [Google Scholar] [CrossRef]
- Pendón, M.D.; Madeira, J.V., Jr.; Romanin, D.E.; Rumbo, M.; Gombert, A.K.; Garrote, G.L. A Biorefinery Concept for the Production of Fuel Ethanol, Probiotic Yeast, and Whey Protein from a by-Product of the Cheese Industry. Appl. Microbiol. Biotechnol. 2021, 105, 3859–3871. [Google Scholar] [CrossRef]
- Leandro, M.J.; Marques, S.; Ribeiro, B.; Santos, H.; Fonseca, C. Integrated Process for Bioenergy Production and Water Recycling in the Dairy Industry: Selection of Kluyveromyces Strains for Direct Conversion of Concentrated Lactose-Rich Streams into Bioethanol. Microorganisms 2019, 7, 545. [Google Scholar] [CrossRef] [PubMed]
- Baptista, M.; Domingues, L. Kluyveromyces marxianus as a Microbial Cell Factory for Lignocellulosic Biomass Valorisation. Biotechnol. Adv. 2022, 60, 108027. [Google Scholar] [CrossRef]
- Ballesteros, M.; Oliva, J.M.; Negro, M.J.; Manzanares, P.; Ballesteros, I. Ethanol from Lignocellulosic Materials by a Simultaneous Saccharification and Fermentation Process (SFS) with Kluyveromyces marxianus CECT 10875. Process Biochem. 2004, 39, 1843–1848. [Google Scholar] [CrossRef]
- Suryawati, L.; Wilkins, M.R.; Bellmer, D.D.; Huhnke, R.L.; Maness, N.O.; Banat, I.M. Simultaneous Saccharification and Fermentation of Kanlow Switchgrass Pretreated by Hydrothermolysis Using Kluyveromyces marxianus IMB4. Biotechnol. Bioeng. 2008, 101, 894–902. [Google Scholar] [CrossRef] [PubMed]
- Charoensopharat, K.; Thanonkeo, P.; Thanonkeo, S.; Yamada, M. Ethanol Production from Jerusalem Artichoke Tubers at High Temperature by Newly Isolated Thermotolerant Inulin-Utilizing Yeast Kluyveromyces marxianus Using Consolidated Bioprocessing. Antonie Leeuwenhoek 2015, 108, 173–190. [Google Scholar] [CrossRef] [PubMed]
- Panelli, S.; Brambati, E.; Bonacina, C.; Feligini, M. Diversity of Fungal Flora in Raw Milk from the Italian Alps in Relation to Pasture Altitude. SpringerPlus 2013, 2, 405. [Google Scholar] [CrossRef] [PubMed]
- Tofalo, R.; Fasoli, G.; Schirone, M.; Perpetuini, G.; Pepe, A.; Corsetti, A.; Suzzi, G. The Predominance, Biodiversity and Biotechnological Properties of Kluyveromyces marxianus in the Production of Pecorino Di Farindola Cheese. Int. J. Food Microbiol. 2014, 187, 41–49. [Google Scholar] [CrossRef]
- Han, X.; Zhang, L.J.; Wu, H.Y.; Wu, Y.F.; Zhao, S.N. Investigation of Microorganisms Involved in Kefir Biofilm Formation. Antonie Leeuwenhoek 2018, 111, 2361–2370. [Google Scholar] [CrossRef]
- Lachance, M.A. Yeasts from Natural Tequila Formation. Antonie Leeuwenhoek 1995, 68, 151–160. [Google Scholar] [CrossRef]
- Buenrostro-Figueroa, J.; Tafolla-Arellano, J.C.; Flores-Gallegos, A.C.; Rodríguez-Herrera, R.; De la Garza-Toledo, H.; Aguilar, C.N. Native Yeasts for Alternative Utilization of Overripe Mango Pulp for Ethanol Production. Rev. Argent Microbiol. 2018, 50, 173–177. [Google Scholar] [CrossRef]
- Schroeder, B.K.; Rogers, J.D.; Johnson, D.A.; Pelter, G. Occurrence of Kluyveromyces marxianus var. marxianus Causing Onion Soft Rot in the Columbia Basin of Washington State. Plant Dis. 2007, 91, 1059. [Google Scholar] [CrossRef]
- Limtong, S.; Sringiew, C.; Yongmanitchai, W. Production of Fuel Ethanol at High Temperature from Sugar Cane Juice by a Newly Isolated Kluyveromyces marxianus. Bioresour. Technol. 2007, 98, 3367–3374. [Google Scholar] [CrossRef] [PubMed]
- Suzuki, T.; Hoshino, T.; Matsushika, A. Draft Genome Sequence of Kluyveromyces marxianus Strain DMB1, Isolated from Sugarcane Bagasse Hydrolysate. Genome Announc. 2014, 2, e00733-14. [Google Scholar] [CrossRef] [PubMed]
- Trapala, J.; Bustos-Jaimes, I.; Manzanares, P.; Bárzana, E.; Montiel, C. Purification and Characterization of an Inulinase Produced by a Kluyveromyces marxianus Strain Isolated from Blue Agave Bagasse. Protein Expr. Purif. 2020, 176, 105718. [Google Scholar] [CrossRef] [PubMed]
- Serrat, M.; Bermúdez, R.C.; Villa, T.G. Production, Purification, and Characterization of a Polygalacturonase from a New Strain of Kluyveromyces marxianus Isolated from Coffee Wet-Processing Wastewater. Appl. Biochem. Biotechnol. 2002, 97, 193–208. [Google Scholar] [CrossRef] [PubMed]
- Avchar, R.; Lanjekar, V.; Baghela, A. Bioprospecting Thermotolerant Yeasts from Distillery Effluent and Molasses for High-Temperature Ethanol Production. J. Appl. Microbiol. 2022, 132, 1134–1151. [Google Scholar] [CrossRef]
- Atter, A.; Diaz, M.; Tano-Debrah, K.; Kunadu, A.P.H.; Mayer, M.J.; Colquhoun, I.J.; Nielsen, D.S.; Baker, D.; Narbad, A.; Amoa-Awua, W. Microbial Diversity and Metabolite Profile of Fermenting Millet in the Production of Hausa Koko, a Ghanaian Fermented Cereal Porridge. Front. Microbiol. 2021, 12, 681983. [Google Scholar] [CrossRef]
- Coton, E.; Coton, M.; Levert, D.; Casaregola, S.; Sohier, D. Yeast Ecology in French Cider and Black Olive Natural Fermentations. Int. J. Food Microbiol. 2006, 108, 130–135. [Google Scholar] [CrossRef]
- Vigentini, I.; Maghradze, D.; Petrozziello, M.; Bonello, F.; Mezzapelle, V.; Valdetara, F.; Failla, O.; Foschino, R. Indigenous Georgian Wine-Associated Yeasts and Grape Cultivars to Edit the Wine Quality in a Precision Oenology Perspective. Front. Microbiol. 2016, 7, 352. [Google Scholar] [CrossRef][Green Version]
- Freitas Schwan, R.; Mendonça, A.T.; Da Silva, J.J.; Rodrigues, V.; Wheals, A.E. Microbiology and Physiology of Cachaça (Aguardente) Fermentations. Antonie Leeuwenhoek 2001, 79, 89–96. [Google Scholar] [CrossRef]
- Escalante-Minakata, P.; Blaschek, H.P.; Barba De La Rosa, A.P.; Santos, L.; De León-Rodríguez, A. Identification of Yeast and Bacteria Involved in the Mezcal Fermentation of Agave salmiana. Lett. Appl. Microbiol. 2008, 46, 626–630. [Google Scholar] [CrossRef]
- Verdugo Valdez, A.; Segura Garcia, L.; Kirchmayr, M.; Ramírez Rodríguez, P.; González Esquinca, A.; Coria, R.; Gschaedler Mathis, A. Yeast Communities Associated with Artisanal Mezcal Fermentations from Agave salmiana. Antonie Leeuwenhoek 2011, 100, 497–506. [Google Scholar] [CrossRef] [PubMed]
- Nolasco-Cancino, H.; Santiago-Urbina, J.A.; Wacher, C.; Ruíz-Terán, F. Predominant Yeasts during Artisanal Mezcal Fermentation and Their Capacity to Ferment Maguey Juice. Front. Microbiol. 2018, 9, 2900. [Google Scholar] [CrossRef] [PubMed]
- Belloch, C.; Barrio, E.; García, M.D.; Querol, A. Inter- and Intraspecific Chromosome Pattern Variation in the Yeast Genus Kluyveromyces. Yeast 1998, 14, 1341–1354. [Google Scholar] [CrossRef]
- Lane, M.M.; Burke, N.; Karreman, R.; Wolfe, K.H.; O’Byrne, C.P.; Morrissey, J.P. Physiological and Metabolic Diversity in the Yeast Kluyveromyces marxianus. Antonie Leeuwenhoek 2011, 100, 507–519. [Google Scholar] [CrossRef] [PubMed]
- Fasoli, G.; Barrio, E.; Tofalo, R.; Suzzi, G.; Belloch, C. Multilocus Analysis Reveals Large Genetic Diversity in Kluyveromyces marxianus Strains Isolated from Parmigiano Reggiano and Pecorino Di Farindola Cheeses. Int. J. Food Microbiol. 2016, 233, 1–10. [Google Scholar] [CrossRef]
- Tittarelli, F.; Varela, J.A.; Gethins, L.; Stanton, C.; Ross, R.P.; Suzzi, G.; Grazia, L.; Tofalo, R.; Morrissey, J.P. Development and Implementation of Multilocus Sequence Typing to Study the Diversity of the Yeast Kluyveromyces marxianus in Italian Cheeses. Microb. Genom. 2018, 4, e000153. [Google Scholar] [CrossRef]
- Martini, S.; Bonazzi, M.; Malorgio, I.; Pizzamiglio, V.; Tagliazucchi, D.; Solieri, L. Characterization of Yeasts Isolated from Parmigiano Reggiano Cheese Natural Whey Starter: From Spoilage Agents to Potential Cell Factories for Whey Valorization. Microorganisms 2021, 9, 2288. [Google Scholar] [CrossRef] [PubMed]
- Ortiz-Merino, R.A.; Varela, J.A.; Coughlan, A.Y.; Hoshida, H.; da Silveira, W.B.; Wilde, C.; Kuijpers, N.G.A.; Geertman, J.M.; Wolfe, K.H.; Morrissey, J.P. Ploidy Variation in Kluyveromyces marxianus Separates Dairy and Non-Dairy Isolates. Front. Genet. 2018, 9, 94. [Google Scholar] [CrossRef]
- Escalante, A.; López Soto, D.R.; Velázquez Gutiérrez, J.E.; Giles-Gómez, M.; Bolívar, F.; López-Munguía, A. Pulque, a Traditional Mexican Alcoholic Fermented Beverage: Historical, Microbiological, and Technical Aspects. Front. Microbiol. 2016, 7, 1026. [Google Scholar] [CrossRef] [PubMed]
- Villarreal-Morales, S.L.; Montañez-Saenz, J.C.; Aguilar-González, C.N.; Rodriguez-Herrera, R. Chapter 11—Metagenomics of Traditional Beverages. In Advances in Biotechnology for Food Industry; Holban, A.M., Grumezescu, A.M., Eds.; Academic Press: Cambridge, MA, USA, 2018; pp. 301–326. ISBN 978-0-12-811443-8. [Google Scholar]
- Arellano-Plaza, M.; Paez-Lerma, J.B.; Soto-Cruz, N.O.; Kirchmayr, M.R.; Gschaedler Mathis, A. Mezcal Production in Mexico: Between Tradition and Commercial Exploitation. Front. Sustain. Food Syst. 2022, 6, 832532. [Google Scholar] [CrossRef]
- Colunga-Garcíamarín, P.; May-Pat, F. Agave Studies in Yucatan, Mexico. I. Past and Present Germplasm Diversity and Uses. Econ. Bot. 1993, 47, 312–327. [Google Scholar] [CrossRef]
- Herrera Solórzano, M.C. Identificación Polifásica de Levaduras y Bacterias Ácido Aisladas de Aguamiel, Pulque y Semilla; Centro de Investigación Científica y de Educación Superior de Ensenada: Ensenada, Baja California, México, 2008. [Google Scholar]
- Pérez-Brito, D. Molecular Characterization of Kluyveromyces marxianus Strains Isolated from Agave fourcroydes (Lem.) in Yucatan, Mexico. Mol. Biotechnol. 2007, 37, 181–186. [Google Scholar] [CrossRef] [PubMed]
- O’Donnell, K. Fusarium and Its near Relatives. In The fungal Holomorph: Mitotic, Meiotic and Pleomorphic Speciation in Fungal Systematics; Reynolds, D.R., Taylor, J.W., Eds.; CABI Publishing: Wallingford, UK, 1993; pp. 225–232. [Google Scholar]
- White, T.J.; Bruns, T.; Lee, S.; Taylor, J. Amplification and Direct Sequencing of Fungal Ribosomal RNA Genes for Phylogenetics. In PCR Protocols; Innis, M.A., Gelfand, D.H., Sninsky, J.J., White, T.J., Eds.; Academic Press: Cambridge, MA, USA, 1990; pp. 315–322. [Google Scholar]
- Hall, T.A. BIOEDIT: A User-Friendly Biological Sequence Alignment Editor and Analysis Program for Windows 95/98/NT. Nucleic Acids Symp. Ser. 1999, 41, 95–98. [Google Scholar]
- Altschul, S.F.; Gish, W.; Miller, W.; Myers, E.W.; Lipman, D.J. Basic Local Alignment Search Tool. J. Mol. Biol. 1990, 215, 403–410. [Google Scholar] [CrossRef] [PubMed]
- Kumar, S.; Stecher, G.; Tamura, K. MEGA7: Molecular Evolutionary Genetics Analysis Version 7.0 for Bigger Datasets. Mol. Biol. Evol. 2016, 33, 1870–1874. [Google Scholar] [CrossRef] [PubMed]
- da Silva-Filho, E.A.; dos Santos, S.K.B.; do Monte Resende, A.; de Morais, J.O.F.; de Morais, M.A.; Simões, D.A. Yeast Population Dynamics of Industrial Fuel-Ethanol Fermentation Process Assessed by PCR-Fingerprinting. Antonie Leeuwenhoek 2005, 88, 13–23. [Google Scholar] [CrossRef]
- Barnett, J.A.; Payne, R.W.; Yarrow, D.; Barnett, L. Yeasts: Characteristics and Identification; Cambridge University Press: Cambridge, UK, 2000; ISBN 9780521573962. [Google Scholar]
- Kurtzman, C.; Fell, J.W.; Boekhout, T. The Yeasts: A Taxonomic Study, 5th ed.; Elsevier Science: Amsterdam, The Netherlands, 2010; ISBN 9780444521491. [Google Scholar]
- Ram, A.F.J.; Klis, F.M. Identification of Fungal Cell Wall Mutants Using Susceptibility Assays Based on Calcofluor White and Congo Red. Nat. Protoc. 2006, 1, 2253–2256. [Google Scholar] [CrossRef]
- Soro, A.B.; Oliveira, M.; O’Donnell, C.P.; Tiwari, B.K. Ultrasound Assisted Modulation of Yeast Growth and Inactivation Kinetics. Ultrason. Sonochem. 2021, 80, 105819. [Google Scholar] [CrossRef]
- Mukherjee, V.; Steensels, J.; Lievens, B.; Van de Voorde, I.; Verplaetse, A.; Aerts, G.; Willems, K.A.; Thevelein, J.M.; Verstrepen, K.J.; Ruyters, S. Phenotypic Evaluation of Natural and Industrial Saccharomyces Yeasts for Different Traits Desirable in Industrial Bioethanol Production. Appl. Microbiol. Biotechnol. 2014, 98, 9483–9498. [Google Scholar] [CrossRef]
- Pedraza, L.; Flores, A.; Toribio, H.; Quintero, R.; Le Borgne, S.; Moss-Acosta, C.; Martinez, A. Sequential Thermochemical Hydrolysis of Corncobs and Enzymatic Saccharification of the Whole Slurry Followed by Fermentation of Solubilized Sugars to Ethanol with the Ethanologenic Strain Escherichia coli MS04. Bioenergy Res. 2016, 9, 1046–1052. [Google Scholar] [CrossRef]
- Castillo-Plata, A.K.; Sigala, J.C.; Lappe-Oliveras, P.; Le Borgne, S. KCL/KOH Supplementation Improves Acetic Acid Tolerance and Ethanol Production in a Thermotolerant Strain of Kluyveromyces marxianus Isolated from Henequen (Agave fourcroydes). Rev. Mex. Ing. Quim. 2022, 21, Bio2567. [Google Scholar] [CrossRef]
- Lachance, M.A. Kluyveromyces van Der Walt (1971). In The Yeasts; Kurtzman, C.P., Fell, J.W., Boekhout, T., Eds.; Elsevier: Amsterdam, The Netherlands, 2011; Volume 2, pp. 471–481. ISBN 9780444521491. [Google Scholar]
- Costa-de-Oliveira, S.; Silva, A.P.; Miranda, I.M.; Salvador, A.; Azevedo, M.M.; Munro, C.A.; Rodrigues, A.G.; Pina-Vaz, C. Determination of Chitin Content in Fungal Cell Wall: An Alternative Flow Cytometric Method. Cytom. A 2013, 83 A, 324–328. [Google Scholar] [CrossRef]
- Kurtzman, C.P.; Robnett, C.J. Identification and Phylogeny of Ascomycetous Yeasts from Analysis of Nuclear Large Subunit (26S) Ribosomal DNA Partial Sequences. Antonie Leeuwenhoek 1998, 73, 331–371. [Google Scholar] [CrossRef] [PubMed]
- Belloch, C.; Fernández-Espinar, T.; Querol, A.; Dolores García, M.; Barrio, E. An Analysis of Inter- and Intraspecific Genetic Variabilities in the Kluyveromyces marxianus Group of Yeast Species for the Reconsideration of the K. lactis Taxon. Yeast 2002, 19, 257–268. [Google Scholar] [CrossRef] [PubMed]
- Tofalo, R.; Perpetuini, G.; Fasoli, G.; Schirone, M.; Corsetti, A.; Suzzi, G. Biodiversity Study of Wine Yeasts Belonging to the “Terroir” of Montepulciano d’Abruzzo “Colline Teramane” Revealed Saccharomyces cerevisiae Strains Exhibiting Atypical and Unique 5.8S-ITS Restriction Patterns. Food Microbiol. 2014, 39, 7–12. [Google Scholar] [CrossRef]
- Baleiras Couto, M.M.; Hartog, B.J.; Huis In’t Veld, J.H.J.; Hofstra, H.; Van Der Vossen, J.M.B.M. Identification of Spoilage Yeasts in a Food-Production Chain by Microsatellite Polymerase Chain Reaction Fingerprinting. Food Microbiol. 1996, 13, 59–67. [Google Scholar] [CrossRef]
- Bigey, F.; Segond, D.; Friedrich, A.; Guezenec, S.; Bourgais, A.; Huyghe, L.; Agier, N.; Nidelet, T.; Sicard, D. Evidence for Two Main Domestication Trajectories in Saccharomyces cerevisiae Linked to Distinct Bread-Making Processes. Curr. Biol. 2021, 31, 722–732.e5. [Google Scholar] [CrossRef]
- Van Heerden, A.; Kock, J.L.F.; Botes, P.J.; Pohl, C.H.; Strauss, C.J.; Van Wyk, P.W.J.; Nigam, S. Ascospore Release from Bottle-Shaped Asci in Dipodascus albidus. FEMS Yeast Res. 2005, 5, 1185–1190. [Google Scholar] [CrossRef]
- Hughes, S.R.; Qureshi, N.; López-Núñez, J.C.; Jones, M.A.; Jarodsky, J.M.; Galindo-Leva, L.Á.; Lindquist, M.R. Utilization of Inulin-Containing Waste in Industrial Fermentations to Produce Biofuels and Bio-Based Chemicals. World J. Microbiol. Biotechnol. 2017, 33, 78. [Google Scholar] [CrossRef]
- de Paiva, L.C.; Diniz, R.H.S.; Vidigal, P.M.P.; de Oliveira Mendes, T.A.; Santana, M.F.; Cerdán, M.E.; González-Siso, M.I.; da Silveira, W.B. Genomic Analysis and Lactose Transporter Expression in Kluyveromyces marxianus CCT 7735. Fungal Biol. 2019, 123, 687–697. [Google Scholar] [CrossRef]
- Ortiz-Basurto, R.I.; Pourcelly, G.; Doco, T.; Williams, P.; Dormer, M.; Belleville, M.P. Analysis of the Main Components of the Aguamiel Produced by the Maguey-Pulquero (Agave mapisaga) throughout the Harvest Period. J. Agric. Food Chem. 2008, 56, 3682–3687. [Google Scholar] [CrossRef] [PubMed]
- Romero-López, M.R.; Osorio-Díaz, P.; Flores-Morales, A.; Robledo, N.; Mora-Escobedo, R. Chemical Composition, Antioxidant Capacity and Prebiotic Effect of Aguamiel (Agave atrovirens) during in vitro Fermentation. Rev. Mex. Ing. Quim. 2015, 14, 281–292. [Google Scholar]
- Michel-Cuello, C.; Juárez-Flores, B.I.; Aguirre-Rivera, J.R.; Pinos-Rodríguez, J.M. Quantitative Characterization of Nonstructural Carbohydrates of Mezcal Agave (Agave salmiana Otto Ex Salm-Dick). J. Agric. Food Chem. 2008, 56, 5753–5757. [Google Scholar] [CrossRef]
- Varela, J.A.; Puricelli, M.; Ortiz-Merino, R.A.; Giacomobono, R.; Braun-Galleani, S.; Wolfe, K.H.; Morrissey, J.P. Origin of Lactose Fermentation in Kluyveromyces lactis by Interspecies Transfer of a Neo-Functionalized Gene Cluster during Domestication. Curr. Biol. 2019, 29, 4284–4290.e2. [Google Scholar] [CrossRef] [PubMed]
- Pereira, I.; Madeira, A.; Prista, C.; Loureiro-Dias, M.C.; Leandro, M.J. Characterization of New Polyol/H+ Symporters in Debaryomyces hansenii. PLoS ONE 2014, 9, e88180. [Google Scholar] [CrossRef][Green Version]
- Hor, S.; Kongkeitkajorn, M.B.; Reungsang, A. Sugarcane Bagasse-Based Ethanol Production and Utilization of Its Vinasse for Xylitol Production as an Approach in Integrated Biorefinery. Fermentation 2022, 8, 340. [Google Scholar] [CrossRef]
- Barnett, J.A.; Kornberg, H.L. The Utilization by Yeasts of Acids of the Tricarboxylic Acid Cycle. J. Gen. Microbiol. 1960, 23, 65–82. [Google Scholar] [CrossRef]
- Gao, L.; Liu, Y.; Sun, H.; Li, C.; Zhao, Z.; Liu, G. Advances in Mechanisms and Modifications for Rendering Yeast Thermotolerance. J. Biosci. Bioeng. 2016, 121, 599–606. [Google Scholar] [CrossRef]
- Lip, K.Y.F.; García-Ríos, E.; Costa, C.E.; Guillamón, J.M.; Domingues, L.; Teixeira, J.; van Gulik, W.M. Selection and Subsequent Physiological Characterization of Industrial Saccharomyces cerevisiae Strains during Continuous Growth at Sub- and- Supra Optimal Temperatures. Biotechnol. Rep. 2020, 26, e00462. [Google Scholar] [CrossRef]
- Wang, Z.; Qi, Q.; Lin, Y.; Guo, Y.; Liu, Y.; Wang, Q. QTL Analysis Reveals Genomic Variants Linked to High-Temperature Fermentation Performance in the Industrial Yeast. Biotechnol. Biofuels 2019, 12, 59. [Google Scholar] [CrossRef]
- Lehnen, M.; Ebert, B.E.; Blank, L.M. Elevated Temperatures Do Not Trigger a Conserved Metabolic Network Response among Thermotolerant Yeasts. BMC Microbiol. 2019, 19, 100. [Google Scholar] [CrossRef]
- Montini, N.; Doughty, T.W.; Domenzain, I.; Fenton, D.A.; Baranov, P.V.; Harrington, R.; Nielsen, J.; Siewers, V.; Morrissey, J.P. Identification of a Novel Gene Required for Competitive Growth at High Temperature in the Thermotolerant Yeast Kluyveromyces marxianus. Microbiology (Reading) 2022, 168, 001148. [Google Scholar] [CrossRef] [PubMed]
- Ribeiro, R.A.; Bourbon-Melo, N.; Sá-Correia, I. The Cell Wall and the Response and Tolerance to Stresses of Biotechnological Relevance in Yeasts. Front. Microbiol. 2022, 13, 953479. [Google Scholar] [CrossRef]
- Mukherjee, V.; Radecka, D.; Aerts, G.; Verstrepen, K.J.; Lievens, B.; Thevelein, J.M. Phenotypic Landscape of Non-Conventional Yeast Species for Different Stress Tolerance Traits Desirable in Bioethanol Fermentation. Biotechnol. Biofuels 2017, 10, 216. [Google Scholar] [CrossRef]
- Deparis, Q.; Claes, A.; Foulquié-Moreno, M.R.; Thevelein, J.M. Engineering Tolerance to Industrially Relevant Stress Factors in Yeast Cell Factories. FEMS Yeast Res. 2017, 17, fox036. [Google Scholar] [CrossRef]
- Piper, P.W. The Heat Shock and Ethanol Stress Responses of Yeast Exhibit Extensive Similarity and Functional Overlap. FEMS Microbiol. Lett. 1995, 134, 12–27. [Google Scholar] [CrossRef]
- Guaragnella, N.; Bettiga, M. Acetic Acid Stress in Budding Yeast: From Molecular Mechanisms to Applications. Yeast 2021, 38, 391–400. [Google Scholar] [CrossRef] [PubMed]
- Field, S.J.; Ryden, P.; Wilson, D.; James, S.A.; Roberts, I.N.; Richardson, D.J.; Waldron, K.W.; Clarke, T.A. Identification of Furfural Resistant Strains of Saccharomyces cerevisiae and Saccharomyces paradoxus from a Collection of Environmental and Industrial Isolates. Biotechnol. Biofuels 2015, 8, 33. [Google Scholar] [CrossRef] [PubMed]
- Ujor, V.C.; Okonkwo, C.C. Microbial Detoxification of Lignocellulosic Biomass Hydrolysates: Biochemical and Molecular Aspects, Challenges, Exploits and Future Perspectives. Front. Bioeng. Biotechnol. 2022, 10, 1061667. [Google Scholar] [CrossRef] [PubMed]
- Kosaka, T.; Tsuzuno, T.; Nishida, S.; Pattanakittivorakul, S.; Murata, M.; Miyakawa, I.; Lertwattanasakul, N.; Limtong, S.; Yamada, M. Distinct Metabolic Flow in Response to Temperature in Thermotolerant Kluyveromyces marxianus. Appl. Environ. Microbiol. 2022, 88, e020062. [Google Scholar] [CrossRef]
- Haclsalihoglu, B.; Holyavkin, C.; Topaloglu, A.; Klsakesen, H.I.; Cakar, Z.P. Genomic and Transcriptomic Analysis of a Coniferyl Aldehyde-Resistant Saccharomyces cerevisiae Strain Obtained by Evolutionary Engineering. FEMS Yeast Res. 2019, 19, foz021. [Google Scholar] [CrossRef] [PubMed]
- Bang, K.H.; Lee, D.W.; Park, H.M.; Rhee, Y.H. Inhibition of Fungal Cell Wall Synthesizing Enzymes by Trans-Cinnamaldehyde. Biosci. Biotechnol. Biochem. 2000, 64, 1061–1063. [Google Scholar] [CrossRef] [PubMed]
- Vadkertiová, R.; Sláviková, E. Metal Tolerance of Yeasts Isolated from Water, Soil and Plant Environments. J. Basic Microbiol. 2006, 46, 145–152. [Google Scholar] [CrossRef] [PubMed]
- Tang, X.; Sousa, L.D.C.; Jin, M.; Chundawat, S.P.S.; Chambliss, C.K.; Lau, M.W.; Xiao, Z.; Dale, B.E.; Balan, V. Designer Synthetic Media for Studying Microbial-catalyzed Biofuel Production. Biotechnol. Biofuels 2015, 8, 1. [Google Scholar] [CrossRef] [PubMed]
- Sandoval-Nuñez, D.; Arellano-Plaza, M.; Gschaedler, A.; Arrizon, J.; Amaya-Delgado, L. A Comparative Study of Lignocellulosic Ethanol Productivities by Kluyveromyces marxianus and Saccharomyces cerevisiae. Clean Technol. Environ. Policy 2018, 20, 1491–1499. [Google Scholar] [CrossRef]

| Isolate | Origin |
|---|---|
| ●Kmx11 | Pulque seed or inoculum |
| ●Kmx14 | Base of a freshly cut henequen leaf |
| ●Kmx15 | Fermented (168 h) pulque |
| ●Kmx16 | Non-fermented cooked henequen juice |
| ●Kmx21 | Non-fermented cooked henequen juice |
| ●Kmx22 | Fermented (48 h) cooked henequen juice |
| ●Kmx24 | Cooked henequen stem |
| Isolate | D1/D2 Domain | % Identity with Type Strain (KY108075) | ITS-5.8S Region | % Identity with Type Strain (NR_111251) |
|---|---|---|---|---|
| ●Kmx11 | OP010195 | 99.6 | OP021667 | 99.55 |
| ●Kmx14 | OP010196 | 100 | OP021667 | 99.85 |
| ●Kmx15 | OP010197 | 99.6 | OP021667 | 99.55 |
| ●Kmx16 | OP010198 | 100 | OP021667 | 99.40 |
| ●Kmx21 | OP010199 | 100 | OP021667 | 99.70 |
| ●Kmx22 | OP010200 | 100 | OP021667 | 100 |
| ●Kmx24 | OP010201 | 100 | MW193124 & | 99.85 |
| Carbon Source | Isolate | [58] | [51] | ||||||
|---|---|---|---|---|---|---|---|---|---|
| Kmx11 | Kmx14 | Kmx15 | Kmx16 | Kmx21 | Kmx22 | Kmx24 | |||
| Fermentation | |||||||||
| Glucose | + | + | + | + | + | + | + | + | + |
| Fructose | + | + | + | + | + | + | + | n.d. | n.d. |
| Galactose | + | w | + | + | + | + | + | d | +, d |
| Xylose | - | - | - | - | - | - | - | n.d. | - |
| Sucrose | + | + | + | + | + | + | + | + | + |
| Maltose | - | - | - | - | - | - | - | - | +, - |
| Lactose | + | + * | + | + | + | + | + * | v | +, - |
| Cellobiose | - | - | - | - | - | - | - | n.d. | d, - |
| Raffinose | + | + | + | + | + | + | + | + | +, - |
| Inulin | + | + | + | + | + | + | + | d | +, - |
| Assimilation | |||||||||
| Glucose | + | + | + | + | + | + | + | + | + |
| Raffinose | + | + | + | + | + | + | + | + | + |
| Maltose | - | - | - | - | - | - | - | +,- | - |
| Rhamnose | - | - | - | - | - | - | - | - | - |
| Sucrose | + | + | + | + | + | + | + | + | + |
| Xylose | d | + | w | + | + | + | + | v | +, - |
| Ribose | - | w | - | - | - | w | d | v | +, - |
| Lactose | + | + | + | + | + | + | + | v | +, - |
| Cellobiose | + | + | + | + | + | d | + | v | +, - |
| Trehalose | - | - | - | - | - | - | - | - | +, - |
| Inulin | + | + | + | + | + | + | + | v | +, - |
| Glycerol | - | w | w | - | - | w | w | v | +, d |
| Ribitol | d | w | d | - | d | w | d | v | +, - |
| Xylitol | + | + | + | + | + | + | + | v | +, - |
| Mannitol | - | w | w | - | w | w | w | v | +, - |
| Sorbitol | d | + | + | w | d | w | + | v | +, - |
| Gluconolactone | - | - | - | - | - | - | - | v | +, - |
| Citrate | - | - | - | w | - | - | - | v | +, - |
| Succinate | w | w | w | + | + | + | w | + | +, d |
| DL-Lactate | + | + | + | + | + | + | w | + | + |
| Ethanol | + | + | + | + | + | + | + | + | +, d |
| Isolate | GLU | EtOH | NaCl | KCl | AA | FUR | CA | Zn | Cd | Cu | Mn | |||||||||||
|---|---|---|---|---|---|---|---|---|---|---|---|---|---|---|---|---|---|---|---|---|---|---|
| (% w/v) | (% v/v) | (g/L) | (g/L) | (g/L) | (g/L) | (mM) | (mM) | (mM) | (mM) | (mM) | ||||||||||||
| 30 °C | 42 °C | 30 °C | 42 °C | 30 °C | 42 °C | 30 °C | 42 °C | 30 °C | 42 °C | 30 °C | 42 °C | 30 °C | 42 °C | 30 °C | 42 °C | 30 °C | 42 °C | 30 °C | 42 °C | 30 °C | 42 °C | |
| ●Kmx11 | 30 | 30 | 7.5 | 2.5 | 25 | 0 | 75 | 50 | 3 | 0 | 2 | 2 | 2 | 1 | 5 | 2.5 | 0.25 | 0 | 4 | 2 | 2 | 2 |
| ●Kmx14 | 30 | 30 | 10 | 7.5 | 37.5 | 37.5 | 75 | 75 | 3 | 1.5 | 1.5 | 2 | 2 | 2 | 5 | 2.5 | 0.5 | 0.25 | 4 | 4 | 2 | 2 |
| ●Kmx15 | 30 | 15 | 5 | 2.5 | 25 | 0 | 75 | 50 | 3 | 1.5 | 2 | 2 | 2 | 1 | 5 | 1.25 | 0.25 | 0 | 4 | 2 | 2 | 0 |
| ●Kmx16 | 30 | 30 | 10 | 5 | 37.5 | 37.5 | 75 | 75 | 3 | 1.5 | 1.5 | 2 | 2 | 2 | 5 | 2.5 | 0.5 | 0.25 | 4 | 4 | 2 | 2 |
| ●Kmx21 | 30 | 30 | 10 | 5 | 37.5 | 37.5 | 75 | 75 | 3 | 1.5 | 1.5 | 2 | 2 | 2 | 5 | 2.5 | 0.5 | 0.25 | 4 | 4 | 2 | 2 |
| ●Kmx22 | 30 | 30 | 7.5 | 5 | 50 | 37.5 | 75 | 75 | 3 | 1.5 | 1.5 | 1.5 | 2 | 2 | 2.5 | 2.5 | 0 | 0 | 4 | 4 | 4 | 2 |
| ●Kmx24 | 30 | 30 | 7.5 | 5 | 37.5 | 37.5 | 75 | 75 | 3 | 1.5 | 1.5 | 2 | 2 | 2 | 5 | 2.5 | 0.5 | 0.25 | 4 | 4 | 2 | 2 |
| Isolate | GLU at 72 h (g/L) | AA at 72 h (g/L) | GLY at 72 h (g/L) | EtOH at 72 h (g/L) | YP/S (a) | EtOH Yield (b) |
|---|---|---|---|---|---|---|
| ●Kmx11 | 0.8 | 3.5 | 0.8 | 15.8 | 0.3 | 56.4% |
| ●Kmx14 | 3.7 | 3.1 | 0.6 | 12.5 | 0.2 | 47.0% |
| ●Kmx15 | 15.0 | 3.1 | 0.2 | 9.0 | 0.2 | 43.3% |
| ●Kmx16 | 0.3 | 3.4 | 0.7 | 13.0 | 0.2 | 45.9% |
| ●Kmx21 | 0.4 | 3.3 | 0.5 | 13.9 | 0.3 | 49.3% |
| ●Kmx22 | 0.3 | 3.4 | 0.9 | 13.8 | 0.2 | 48.8% |
| ●Kmx24 | 0.6 | 3.6 | 0.5 | 13.9 | 0.3 | 49.4% |
Disclaimer/Publisher’s Note: The statements, opinions and data contained in all publications are solely those of the individual author(s) and contributor(s) and not of MDPI and/or the editor(s). MDPI and/or the editor(s) disclaim responsibility for any injury to people or property resulting from any ideas, methods, instructions or products referred to in the content. |
© 2023 by the authors. Licensee MDPI, Basel, Switzerland. This article is an open access article distributed under the terms and conditions of the Creative Commons Attribution (CC BY) license (https://creativecommons.org/licenses/by/4.0/).
Share and Cite
Lappe-Oliveras, P.; Avitia, M.; Sánchez-Robledo, S.D.; Castillo-Plata, A.K.; Pedraza, L.; Baquerizo, G.; Le Borgne, S. Genotypic and Phenotypic Diversity of Kluyveromyces marxianus Isolates Obtained from the Elaboration Process of Two Traditional Mexican Alcoholic Beverages Derived from Agave: Pulque and Henequen (Agave fourcroydes) Mezcal. J. Fungi 2023, 9, 795. https://doi.org/10.3390/jof9080795
Lappe-Oliveras P, Avitia M, Sánchez-Robledo SD, Castillo-Plata AK, Pedraza L, Baquerizo G, Le Borgne S. Genotypic and Phenotypic Diversity of Kluyveromyces marxianus Isolates Obtained from the Elaboration Process of Two Traditional Mexican Alcoholic Beverages Derived from Agave: Pulque and Henequen (Agave fourcroydes) Mezcal. Journal of Fungi. 2023; 9(8):795. https://doi.org/10.3390/jof9080795
Chicago/Turabian StyleLappe-Oliveras, Patricia, Morena Avitia, Sara Darinka Sánchez-Robledo, Ana Karina Castillo-Plata, Lorena Pedraza, Guillermo Baquerizo, and Sylvie Le Borgne. 2023. "Genotypic and Phenotypic Diversity of Kluyveromyces marxianus Isolates Obtained from the Elaboration Process of Two Traditional Mexican Alcoholic Beverages Derived from Agave: Pulque and Henequen (Agave fourcroydes) Mezcal" Journal of Fungi 9, no. 8: 795. https://doi.org/10.3390/jof9080795
APA StyleLappe-Oliveras, P., Avitia, M., Sánchez-Robledo, S. D., Castillo-Plata, A. K., Pedraza, L., Baquerizo, G., & Le Borgne, S. (2023). Genotypic and Phenotypic Diversity of Kluyveromyces marxianus Isolates Obtained from the Elaboration Process of Two Traditional Mexican Alcoholic Beverages Derived from Agave: Pulque and Henequen (Agave fourcroydes) Mezcal. Journal of Fungi, 9(8), 795. https://doi.org/10.3390/jof9080795

